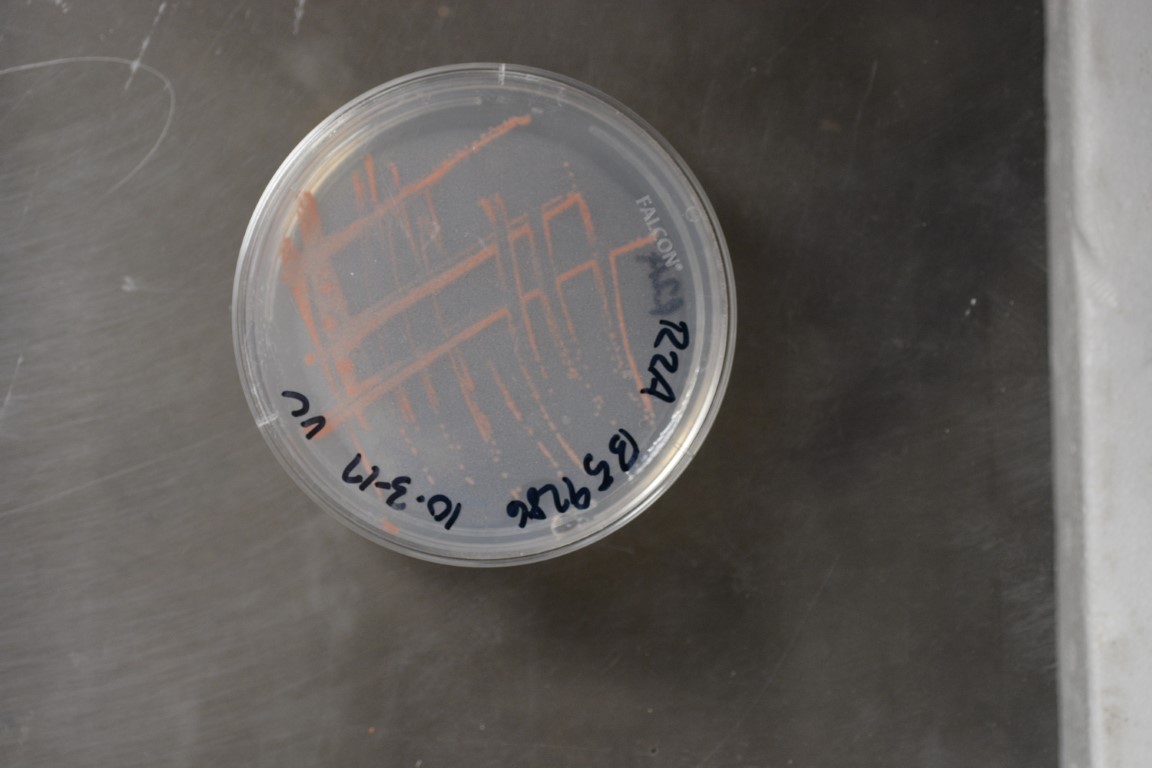

Methylobacterium aquaticum
NRRL B-59286
Accession numbers in other collections:1PO4MD
Source:Dr.K.Venkateswaran,CIT,Jet Propulsion Lab.
Isolated from(substrate):Phoenix spacecraft associated environments
Substrate location:Kennedy Space Center,Cape Canaveral,FL,USA
Growth media:R2A(number 16)
Optimum growth temperature:30C
Strain images:
NRRL_B-59286_16.JPG